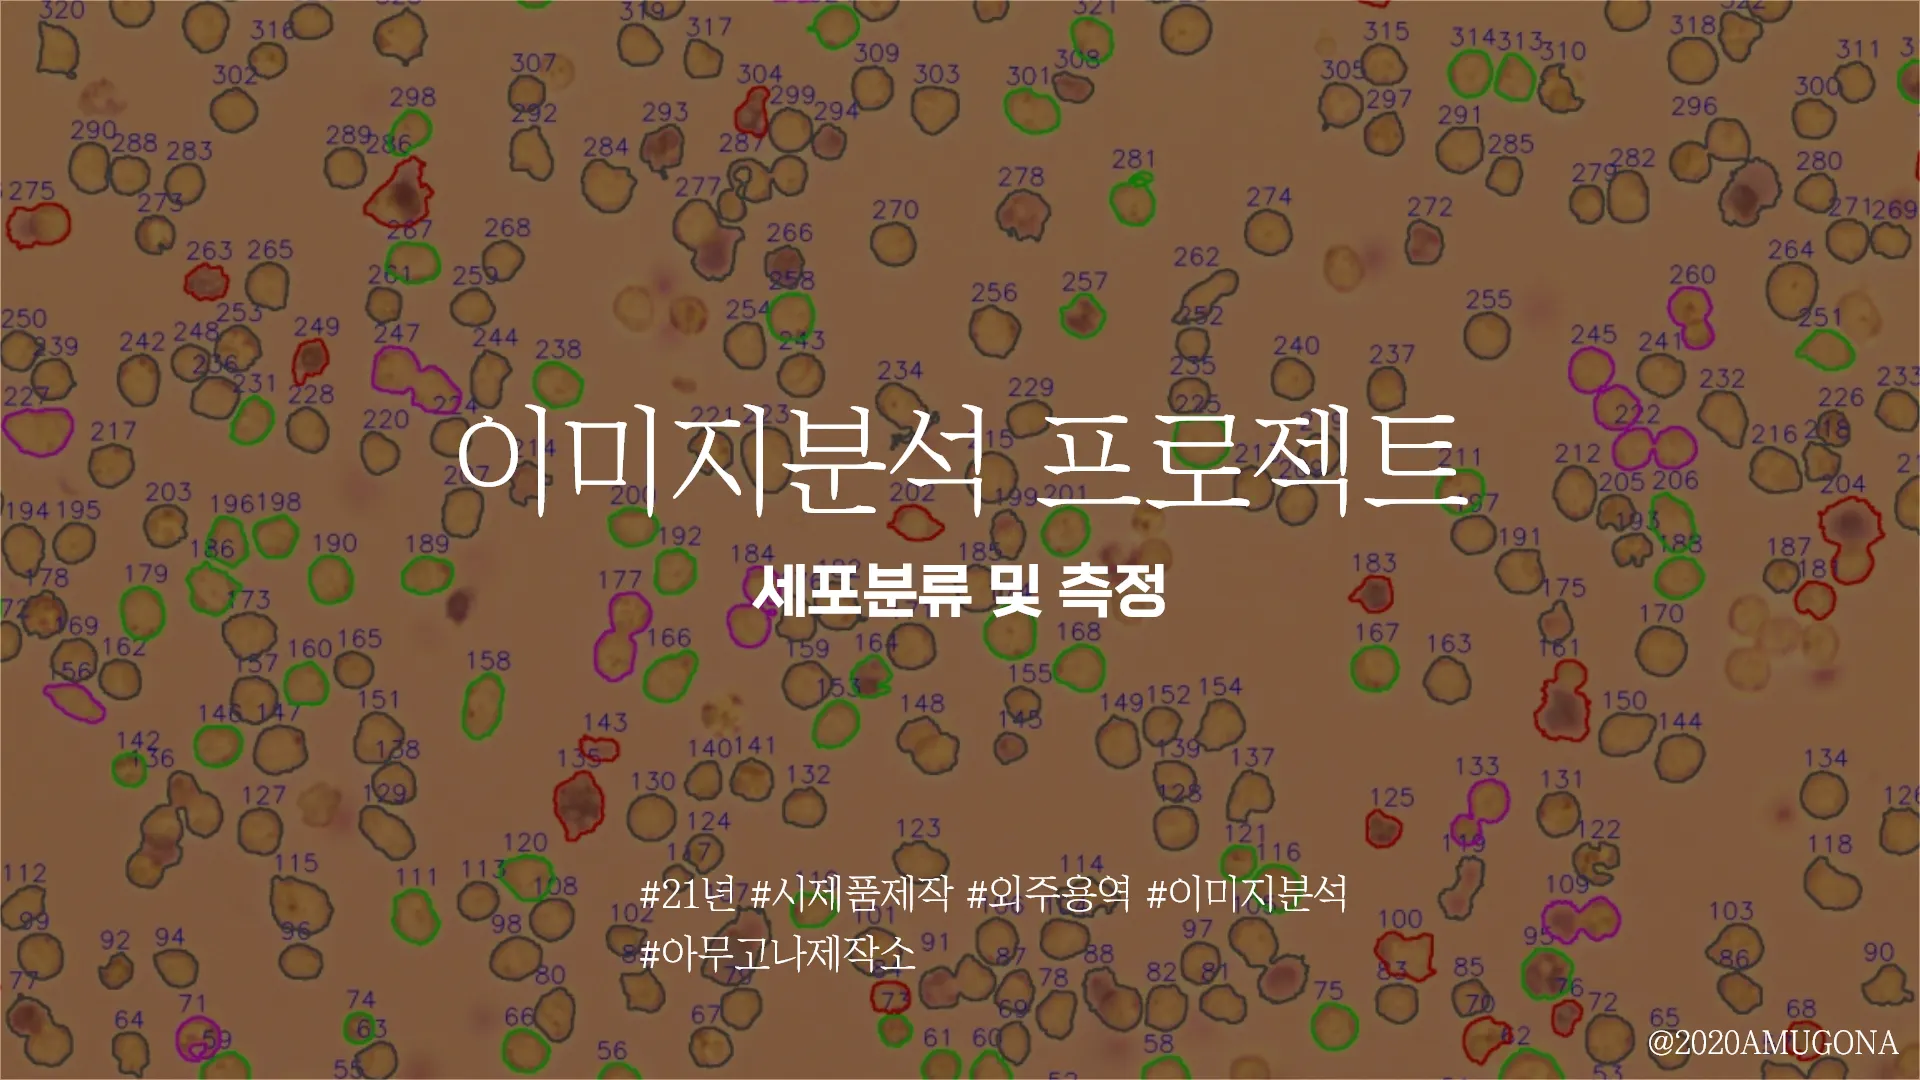

상상을 현실로 만드는 시제품제작업체 아무고나제작소
기구 설계 / 회로 개발 / 소프트웨어 개발
3가지 서비스를 중점으로 시제품을 제작하고 있습니다.
핵심 서비스
제작에 있어서 서비스 한계를 정해두고 있지 않습니다.
서비스의 부분은 제작이 필요한 부분이 있다면 계속해서,
기술/영역은 계속해서 늘려가고 있습니다.
정부지원사업 / 연구 경험을 가지고 있습니다.
•
사업 계획 및 전략을 세운 경험을 다수 가지고 있습니다.
•
사업에 대한 이해가 높아, 필요한 포인트를 잘 만들어드립니다.
설계-회로-코드 서비스를 한 번에 경험 할 수 있습니다.
•
대표가 모든 개발을 담당하여 진행합니다.
•
분야 별 보조가 있지만, 메인 개발은 직접 진행합니다.
•
개발에서 이슈가 있다면 유동적으로 변경 할 수 있습니다.
•
넓은 범위, 다양한 경험으로 아이디어를 실시간으로 발전 시켜드립니다.
프로세스
기능 구현은 대부분의 의뢰에 필요 했었습니다.
•
많은 경험이 쌓이며, 사전 테스트가 줄고 있습니다.
•
의뢰를 하기전 도전 했던 결과를 공유해주면 좋습니다.
•
이런 경우는 무조건 진행 해야합니다.
◦
독특한 구조나 다른 부품을 역설계해야하는 과정
◦
독특한 회로 부품이나 통신 방식인 경우
◦
GUI, DB 등을 포함한 복잡한 방식의 경우
MVP [ Minimum Viable Product ] & 린스타트업 방식을 선호합니다.
•
MVP는 최소기능제품을 이야기 합니다.
◦
오른쪽 그림과 같이 모든 기능을 갖추는 것이 아닌 부분적으로 그 중에서도 핵심적인 기능을 구현하여 제품을 우선 만들어 보는 것 입니다.
1.
핵심기능을 바탕으로 동작 하는 것을 우선 제작
2.
고객피드백을 통해 2차 , 3차시제품 제작
3.
그 후 최종적으로 양산형 제품을 출시
시제품제작 말고 바로 한 번에 양산으로 제품을 만들 수 있나요 ?
•
제품을 판매하는데는 인증과 양산부분에서 매몰비용이 발생
•
MVP 단계에서 테스트와 오류를 잡아내지 못한다면, 제품생산 이후 수정하는 것을 곧 바로 적용 못될 가능성이 큼
•
상당한 비용의 매몰비용이 발생할 것으로 예상되며, 그럼에도 진행하고 싶다면, 저희 사무실이 아닌 제조파트너 업체를 바로 연결시켜드리겠습니다.
아무고나제작소 포트폴리오 
공개된-포트폴리오
Search
아무고나제작소 전체서비스 
외부노출
Search
아무고나제작소 소개 영상
Site Map
•
대표 : 이인규
•
전화 : 0507-1496-1241
•
사업자등록번호 : 519-04-01501
•
경기 수원시 영통구 덕영대로 1731 송관B동 213호


.png&blockId=2ce72157-6be5-42a9-b36c-ee945ba8d8d8)


.png&blockId=1af66735-14ad-487d-873f-2f621568ab0a)



.jpg&blockId=adeb8da1-613e-4823-83ad-d0db1c483b4b)
.jpg&blockId=65fdc7be-33d6-4a00-869d-f1597c931b20)





.jpg&blockId=1a8fbfaa-f7fd-4640-b269-2c4a18ec164a)
.jpg&blockId=03702582-ff9d-42f7-afc9-5fe843a89d28)
.jpg&blockId=11892f82-f35b-4014-9d55-ee7deeed7196)

.png&blockId=70b3f1f3-d6b3-4a12-9c19-83a3223852e7)
.png&blockId=57601d8f-d493-4930-bd18-ce9584409927)































